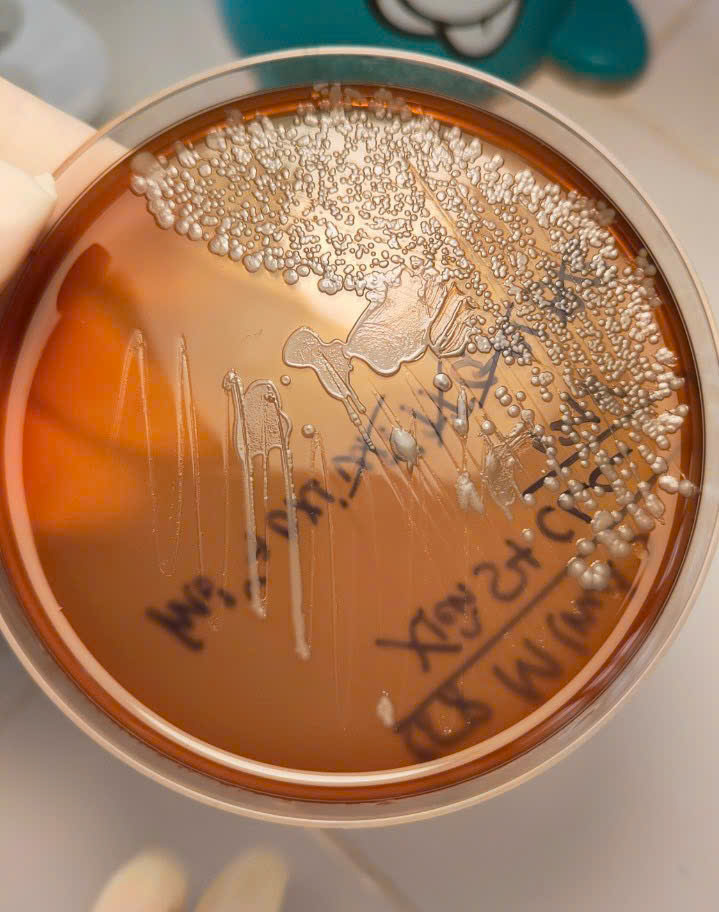
Hình ảnh tin tức CẢNH GIÁC VỚI VI KHUẨN “ĂN THỊT NGƯỜI” WHITMORE

🔵 14/11 - NGÀY THẾ GIỚI PHÒNG CHỐNG BỆNH ĐÁI THÁO ĐƯỜNG 🔵

🔵 14/11 - NGÀY THẾ GIỚI PHÒNG CHỐNG BỆNH ĐÁI THÁO ĐƯỜNG 🔵

💙 12/11 - NGÀY THẾ GIỚI PHÒNG CHỐNG BỆNH VIÊM PHỔI 🌬️


BỆNH LAO – ĐỪNG CHỦ QUAN VỚI NHỮNG CƠN HO KÉO DÀI

🍂🍁 Chủ Động Phòng Chống Dịch Bệnh Mùa Thu - Đông: Bảo Vệ Sức Khỏe Gia Đình Bạn! 🛡️🏡
CẢNH GIÁC VỚI VI KHUẨN “ĂN THỊT NGƯỜI” WHITMORE

🧬 CẢNH BÁO: DEMODEX – “KẺ TÍ HON” GÂY RẮC RỐI TRÊN DA MẶT!

PHÁT HIỆN CA BỆNH LẬU – HẬU QUẢ TỪ “CHUYỆN ẤY” KHÔNG AN TOÀN!

Trước khi bước vào hôn nhân – một quyết định lớn của cuộc đời – việc kiểm tra sức khỏe 🩺tiền hôn nhân là rất cần thiết và trách nhiệm đối với bản thân, người bạn đời và cả thế hệ tương lai.

Một bài học đắt giá về kiểm tra sức khỏe tiền hôn nhân!


Hưởng ứng Tuần lễ dinh dưỡng và phát triển 16-23/10/2025!

Hưởng ứng Ngày Tránh thai thế giới 26/9: Hãy nói "Không" 🚫với mang thai tuổi vị thành niên!

Mùa hè cũng là thời điểm bùng phát nhiều dịch bệnh nguy hiểm ở trẻ em, trong đó có bệnh tay chân miệng.Mọi người hãy thường xuyên quan tâm, theo dõi sức khỏe của trẻ, liên hệ ngay với Bệnh viện Đa

Hưởng ứng tháng cao điểm Dự phòng lây truyền HIV từ mẹ sang con: Xét nghiệm HIV sớm cho mẹ - Hướng tới loại trừ lây truyền HIV từ mẹ sang con!